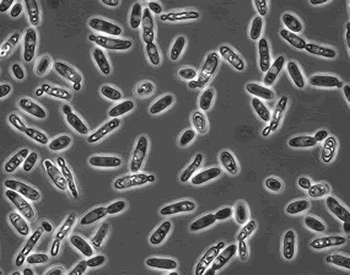

Бреттаномицес в вине
|
|
|
Бреттаномицес (Brettanomyces bruxellensis) – это дрожжи, которые относятся к той же категории, что и наш старый друг Saccharomyces cerevisiae, тысячелетиями сбраживающий сусло в вино.
|
|
Бреттаномицес тоже может сбраживать. Впервые эти дрожжи были обнаружены в пиве (причина порчи пива, вот откуда название, что в переводе означает «Британские плесневые грибы») и сейчас используются некоторыми отчаянными пивоварами для кислого эля. В вине бреттаномицес никогда не используется намеренно, однако часто обнаруживается. «Невидимка» в толпе микробиологических организмов в вине, бреттаномицес развивается очень медленно, может выживать в крайне неблагоприятной среде и использовать для поддержания своей жизнедеятельности незначительный остаточный сахар, этанол (использует этанол как источник энергии) в сухих винах, уксусную кислоту и даже целлюлозу дуба.
Если вы когда-либо пробовали кислый эль, вы знакомы с ароматом, который ассоциируется с бреттаномицесом. Один из ароматов, естественно, кислый: бреттаномицес вырабатывает в большом количестве уксусную кислоту, ту же, что дает уксусный привкус. Но задолго до того, как он попытается превратить вино в уксус, бреттаномицес вырабатывает ароматические компоненты, которые однозначно свидетельствуют о его присутствии: 4-этилфенол (4-ЕР), 4-этилгваякол (4-ЕG), а также изовалериановая кислота, среди других менее заметных компонентов.
|
“Уникальный” – самое подходящее определение для описания этих ароматов. В лучшем случае можно назвать их “пряный” и “запах кожи”. При бóльших концентрациях - это «запах скотного двора» и «лошадиный пот», в тяжелых случаях «мокрая собака» или даже “нечистоты”.
Пряный аромат или тона кожи могут быть допустимы в некоторых винах, но запах конского пота или сточных вод определенно не будут комплементом. Хорошо, плохо или допустимо наличие характерного аромата бреттаномицеса в вине – это из области споров о том, что такое «настоящий» барбекю среди Сатернов: все аргументы субъективны и зависят от личного вкуса, означая, что победителя так и не будет.
Исторически французская долина Рон ассоциируется с красными винами, содержащими бреттаномицес. Некоторые известные винные дома, например, Château de Beaucastel, производят вина, часть из которых имеет характерный органолептический формат, связанный с наличием бреттаномицеса, в определенной степени. Ключевая фраза «в определенной степени». Поклонники говорят, что немного бреттаномицеса придает скорее пряность, чем негативный аромат и подчеркивает terroir. Другие, в основном американцы, наоборот утверждают, что бреттаномицес губит аромат.
|
 |
Итак, вы хотите, чтобы некоторые из таких особенностей присутствовали в вине? Если бы это было так просто. Работа по контролируемому применению бреттаномицеса ведется десятилетиями, однако до сих пор безуспешно. Мы не только не можем контролировать количество бреттаномицеса в вине, мы также не можем полностью избавиться от него в вине. Популярным предложением о том, как избавиться от проблемы бреттаномицеса – это «сжечь винодельню» и начать все сначала. И в этой шутке есть доля правды. Другой вопрос «на миллион долларов» - как предупредить распространение бреттаномицеса. Бреттаномицес может перемещаться от винодельни к винодельне с зараженным разливным вином, с виноградом или через используемое оборудование.
Дубовые бочки – известные переносчики бреттаномицеса. Благодаря способности к метаболизму целлюлозы дуба, эти микроорганизмы могут выживать в дубовых бочках годами. Бреттаномицес находят в древесине на глубине до 8мм, что делает его полное удаление практически невозможным.
Если предложение уничтожить винодельню и начать все сначала вам не подходит, что тогда? Одна из тактик – это локализация, использование новых бочек, купажирование и убедить себя в том, что Вам нравится некоторый бретт- характер ваших вин. Арсенал противо-бреттных инструментов обширен, но в целом, многие из них не эффективны.
|
К наиболее эффективным относятся:
Хорошая санитария: много воды и регулярно применяемые моющие растворы
SO2: двуокись серы - основной антимикробный агент в вине, однако многие штаммы бреттаномицеса приспособились к принятым дозировкам двуокиси серы.
Горячая стерилизация бочек паром: помогает, хотя не может быть абсолютно эффективным средством.
Веркорин: Мощное антимикробное средство, которое через несколько часов после задачи в вино распадается преимущественно на воду CO2 только частично эффективно против бреттаномицеса.
Фильтрация: сделает свою работу, но это может быть затратно. Многие полагают, что только 0.45 – 0.65 мкм фильтрация сможет надежно удалить дрожжи бреттаномицес.
Некоторые винодельни до сих пор не сталкивались с бреттаномицесом (пока еще), некоторые ведут постоянную войну с ним, а некоторые просто не осознают проблему.
Но как насчет производителей, подобных Château Beaucastel, чей бретт характер в винах является абсолютно необходимым для некоторых ценителей? Для них полное отсутствие бреттаномицеса является катастрофой. Все это – личный вкус или есть другие причины? Есть несколько объяснений:
Предпочтения потребителей: В некоторых публикациях отмечено, что французы более толерантны к бреттаномицесу, чем американцы.
Количество 4-EP и 4-EG: В некоторых винах природно содержится меньше молекул прекурсоров, которые Бретт метаболизирует в 4-EP и 4-EG. Обычно, виноград из более прохладных регионов – например, Франции, содержит меньше таких веществ, чем из регионов с более жарким климатом, например Калифорния. Это может означать, что французские вина с меньшей вероятностью будут страдать от бреттаномицеса, чем калифорнийские.
Соотношение 4-EP и 4-EG: 4-EP обычно ассоциируется с запахами скотного двора, в то время как 4-EG с более приятными ароматами гвоздики и пряными тонами. Содержание 4-EP всегда доминирует над 4-EG, но некоторые расы бреттаномицеса и некоторые вина способствуют изменению этого соотношения.
Тип бреттаномицеса: Что если бреттаномицес, обнаруженный в разных регионах имеет разные характеристики? В микробиологии это случается очень часто внутри одной группы. Исследования начинают показывать, что бреттаномицес из Франции радикально отличается от калифорнийского или австралийского.
Возраст вина: бреттаномицес может не только выжить в укупоренной бутылке, но он может также размножаться там и изменять аромат. Вино, в котором обнаружены тона скотного двора, через несколько лет может вонять конским потом. Даже одна клетка, попавшая в бутылку, может изменить вино.
Итак, вы встречались с бреттаномицесом? Даже если вы еще до сих пор не осознали его присутствия, большие шансы того, что вы столкнетесь с ним в своей жизни через некоторое время. Будьте на чеку. Обнаруженные отличительные ароматы могут оказаться визитной карточкой бреттаномицеса.
Erika Szymanski, «The online wine magazine»
|
|
|